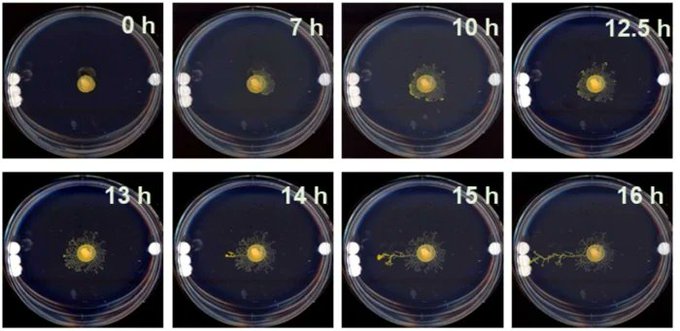

おはようございます!
親の顔より見たファ〇コンチューブ君が挨拶しています!
かわいいね!
今日は加速をかけた食品を使用したヒト官能検査や、Rを使った統計解析の勉強など盛りだくさんです
良き一日を!
#おはようVtuber
【実験背景】
クマムシは、極端な環境下でも生存可能な、カリスマ性を持った微小無脊椎動物です
彼らは、長い進化の歴史を持ち世界中で生息しているにもかかわらず、化石記録に乏しく研究があまり進んでいません
【実験内容2】
彼らはサラさんの脳に、うつ状態になっているかを判断するリード(青)と脳患部に刺激を与えるリード(赤)を持つインプラントを埋め込みました
この2種類のリードをインプラントに持たせることにより、うつ状態の時にのみ脳患部に刺激を与えることが可能です
抵抗性うつ病(治療が効かないうつ病)の患者の脳にインプラントを埋め込み、その疾患を治療する方法が開発されました
インプラントは、患者がうつ状態の時のみ、脳患部に刺激を与えて活性化させるよう設計されています
🐑リプライにて解説🐑
#VRアカデミア #おはようVtuber
https://t.co/rKy3Z8UR8g
感染症のリスクが高い地域では、権威主義的政治(強い中央集権、部外者を排除する態度)を採用する傾向があるかもしれないという調査結果が報告されました
この傾向は、世界中の国で同様にみられています
🐑リプライにて解説🐑
#VRアカデミア #おはようVtuber
https://t.co/PRsvasYqxZ
複数人が同じ物語に魅せられた時、彼らがどんなに離れていても、心拍数が同期する可能性が示唆されました
ただしこの同期現象は、意識障害のある人には見られないそうです
🐑リプライにて解説🐑
#VRアカデミア #おはようVtuber
//doi.org/10.1016/j.celrep.2021.109692
粘菌の仲間であるPhysarum polycephalumが、比較的遠方にある物体の存在について判断する事ができることが明らかになりました
シャーレに1枚or3枚のガラスの円盤を置き、粘菌の動きを観察した結果、全体の70%が写真1枚目のように3枚のガラスの円盤の方に伸びていきました
https://t.co/av67gEUHI8
オリンパス主催の、魅力的な顕微鏡写真を競うコンテストOlympus Image of the Yeah Award 2020の受賞作品
1枚目:共焦点顕微鏡を使用したラット胚の写真
2枚目:チャイロイエヘビの皮膚の写真
3枚目:様々な蝶の羽から集められた鱗たち
4枚目:Lグルタミンとβアラニンの結晶
https://t.co/Vlu6IXdFqh
明晰夢を見る人を被験者に、睡眠中でもリアルタイムに双方向のコミュニケーションが取れるかを検証した研究。被験者に、睡眠中に数学の問題やyes/noで回答できる質問をしました。彼らは、睡眠前に決めておいた目の動きや顔の筋肉の信号で、それらに回答できたそうです。
https://t.co/82tYmsV9sE